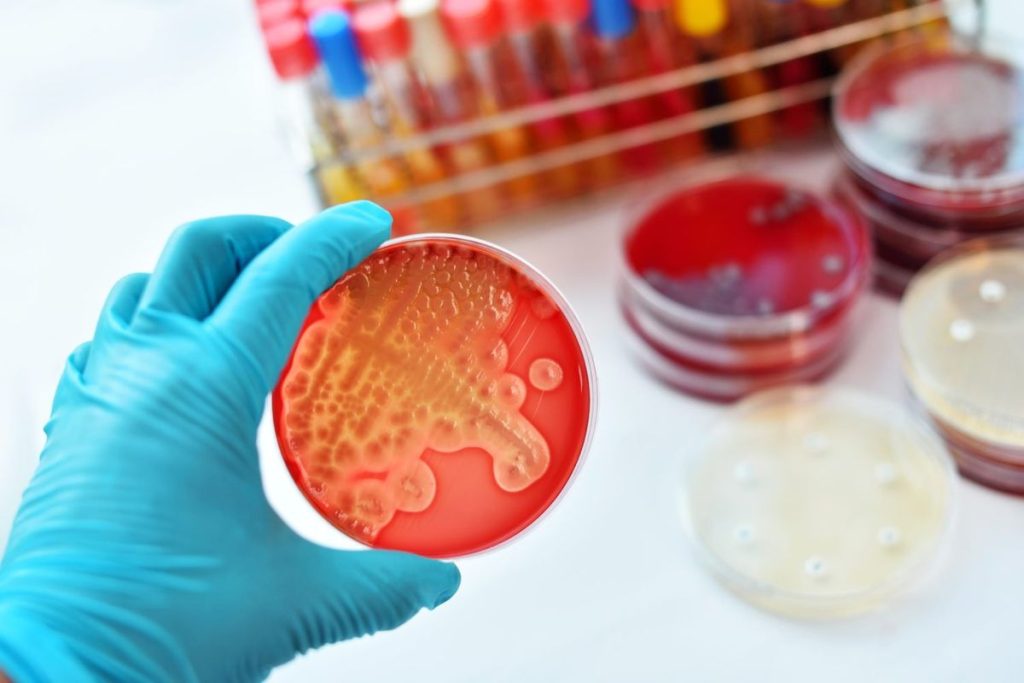
Microbiome

Une peau qui brille en journée, des zones grasses sur le visage, voire quelques imperfections cutanées qui s’invitent sans prévenir : nombreuses sont les personnes à la recherche de la solution miracle pour dompter ce fameux excès de sébum. Pourtant, une piste émergente attire aujourd’hui l’attention : le microbiome cutané. Nouvelle star des recherches dermatologiques et cosmétiques, il devient un sujet incontournable pour comprendre comment rééquilibrer la production de sébum et retrouver une peau saine au quotidien.
Loin des approches décapantes du passé, la tendance actuelle consiste à soutenir l’équilibre du microbiome en respectant l’écosystème cutané naturel. Mais quel est exactement le rôle du microbiome cutané dans l’apparition ou la prévention de l’excès de sébum ? De quelle manière influe-t-il sur l’aspect de la peau et sa capacité à limiter les brillances indésirables ? Plongée dans cet univers invisible autant que fascinant.
Qu’est-ce que le microbiome cutané ?
À première vue, le mot peut sembler complexe, mais comprendre le microbiome cutané revient simplement à parler de l’ensemble des micro-organismes vivant naturellement sur notre peau. Ce vaste ensemble compte diverses bactéries bénéfiques, virus, champignons et autres petits habitants qui, loin d’être de simples squatteurs, participent activement au maintien de la barrière cutanée.
Comme pour la flore intestinale, ces micro-organismes forment un écosystème riche et unique à chaque individu. Ils jouent plusieurs rôles essentiels, notamment en protégeant la peau contre les agressions extérieures, en modulant l’inflammation et en participant à la régulation de la production de sébum. Un véritable allié insoupçonné pour garder la peau en pleine forme.
Comment le microbiome impacte-t-il la production de sébum ?

Le sébum tient mauvaise réputation, mais il ne faut pas oublier qu’il agit comme bouclier naturel. Pourtant, lorsque la balance se rompt, l’excès de sébum favorise brillance, pores dilatés et imperfections cutanées. Pour lutter contre ce phénomène, il existe des solutions comme un gel douche qui lutte contre l’excès de sébum. C’est là que le microbiome entre en scène.
Les bactéries bénéfiques présentes à la surface de la peau dialoguent avec les glandes sébacées et aident à maintenir un niveau optimal de sébum. Pour les personnes concernées par des problèmes de peau spécifiques, il est également possible d’opter pour un gel douche pour l’eczéma atopique. Si ce fragile équilibre du microbiome est perturbé, par exemple après l’utilisation de soins trop agressifs ou en raison d’un mode de vie déséquilibré, on remarque rapidement des signes visibles, tels qu’un film gras tenace ou l’apparition soudaine d’imperfections.
Le rôle des bactéries bénéfiques dans la régulation du sébum
Certaines espèces de bactéries bénéfiques sont connues pour leur capacité à neutraliser les agents pathogènes et à calmer les réactions inflammatoires. Lorsque la proportion de ces bactéries reste stable, elles évitent aux bactéries responsables de l’acné ou d’autres désordres d’envahir le terrain.
Ceci permet à la peau de conserver une hydratation de la peau équilibrée, tout en évitant les pics soudains de production de sébum. Sur le long terme, cela contribue à moins de brillances et à davantage de confort cutané.
Dérèglements du microbiome et conséquences visibles
Un déséquilibre de l’écosystème cutané fragilise la barrière protectrice naturelle de la peau. Cela crée un cercle vicieux : la peau, trop sollicitée, surproduit du sébum en réaction, ce qui nourrit les problèmes déjà présents.
Il suffit parfois d’une routine inadaptée, riche en alcool ou produits décapants, ou même d’une exposition prolongée à la pollution, pour « casser » l’équilibre du microbiome. La conséquence directe se traduit alors par des pores obstrués, des rougeurs et la multiplication des imperfections cutanées.
Pourquoi chercher à préserver l’équilibre du microbiome ?
Redonner tout son rôle à l’écosystème cutané, c’est offrir à la peau plus d’outils pour se défendre seule. Contrairement à certains traitements de choc, miser sur l’équilibre du microbiome conduit généralement à des résultats durables, tant pour limiter l’excès de sébum que pour améliorer globalement l’aspect du teint.
En effet, quand cet écosystème fonctionne harmonieusement, il renforce la barrière cutanée, maintient une bonne hydratation de la peau et protège contre les irritations externes. Cette approche douce et respectueuse transforme peu à peu la perception des solutions anti-brillance, au profit d’une démarche globale et porteuse de sens.
Des effets positifs sur les peaux à tendances grasses

Les peaux mixtes ou grasses bénéficient particulièrement de l’atténuation de l’excès de sébum grâce à un microbiome robuste. Les brillances diminuent au fil du temps, tandis que les zones sensibles retrouvent confort et douceur.
Parallèlement, moins de pores obstrués signifie souvent moins d’imperfections cutanées persistantes. En agissant en profondeur sur l’origine du dérèglement, l’approche centrée sur le microbiome cutané offre une alternative intéressante face aux méthodes astringentes parfois trop radicales.
Impact sur l’hydratation de la peau et la barrière cutanée
La présence de bactéries bénéfiques garantit également une meilleure capacité de rétention d’eau à la surface de l’épiderme. Résultat : la peau n’a plus besoin de produire autant de sébum pour se protéger, ce qui allège la sensation de lourdeur et de gras sur le visage.
Ce maintien de l’intégrité de la barrière cutanée contribue aussi à une moindre sensibilité face aux variations climatiques, aux nettoyages répétés ou aux frottements quotidiens. La flore cutanée bien installée joue donc un rôle clé pour prévenir déséquilibres et inconforts.
Quels gestes adopter pour soutenir l’équilibre du microbiome cutané ?
Pour profiter réellement du potentiel du microbiome cutané sur la gestion de l’excès de sébum, un changement de perspective s’impose dans la routine beauté. Priorité à la douceur et au soutien des mécaniques naturelles de défense de la peau.
Le choix des produits, la fréquence des lavages ou encore le respect de certaines habitudes influencent de façon directe la vitalité de cet écosystème fragile. Miser sur des routines simples, mais efficaces, reste essentiel.
- Sélectionner des nettoyants doux, sans effet décapant, afin de ne pas éliminer les bactéries bénéfiques.
- Utiliser des soins enrichis en prébiotiques ou probiotiques adaptés à la peau du visage.
- Ajuster la fréquence d’exfoliation pour éviter de perturber la flore cutanée.
- Bannir l’excès d’alcool et privilégier des molécules apaisantes et réparatrices.
- Limiter l’exposition à la pollution et prendre soin de nettoyer la peau en douceur chaque jour.
- Veiller à une alimentation variée, car celle-ci influence indirectement l’état de l’écosystème cutané.
Quelques ingrédients-clés à privilégier
Dans le rayon cosmétique, certains actifs gagnent en popularité pour leur action bénéfique sur l’équilibre du microbiome cutané. On retrouve notamment les extraits de ferments, les sucres complexes, ou encore des vitamines apaisantes.
D’autres formules font appel à des extraits végétaux reconnus pour soutenir la barrière cutanée, tels que la centella asiatica ou l’aloe vera. Attention toutefois à sélectionner des synergies douces, sans agents trop abrasifs susceptibles d’appauvrir la flore cutanée.
L’importance de la régularité et de la patience
Rééquilibrer un microbiome ne se fait pas en quelques jours. Une certaine constance s’avère nécessaire pour permettre aux bonnes bactéries de recoloniser l’épiderme et restaurer la barrière originelle.
Adopter une vision à moyen terme facilite l’obtention de résultats visibles sur l’excès de sébum et la clarté du teint. Au fil du temps, la peau paraît mieux protégée et plus résiliente face aux agressions courantes.
L’avenir des soins et les perspectives autour du microbiome cutané
Avec l’intérêt croissant porté au microbiome cutané, de nouvelles recherches voient le jour pour cibler spécifiquement les causes profondes de l’excès de sébum. Innovation et développement de formules toujours plus pointues amènent à repenser la routine visage en profondeur.
Ces avancées promettent une révolution douce, où l’on cherche désormais à travailler avec la nature plutôt que contre elle, pour offrir à chacun(e) une peau saine sans renoncer au confort ni à la simplicité d’utilisation.
Des outils personnalisés pour optimiser la santé de la peau
Certains laboratoires développent déjà des diagnostics visant à analyser la composition du microbiome cutané, afin de recommander des soins précis en fonction du profil individuel. À terme, cette approche ultra-personnalisée pourrait permettre d’obtenir une efficacité renforcée sur la maîtrise du sébum et des imperfections cutanées.
Par ailleurs, des marques misent sur des gammes composées intégralement d’ingrédients biocompatibles, pour redonner à la flore cutanée toute sa diversité utile. Ces soins tendent à remplacer progressivement les routines standardisées centrées uniquement sur la suppression du sébum.
Vers une nouvelle philosophie du soin cutané
Au-delà des cosmétiques, le sujet du microbiome inspire une réflexion globale sur l’hygiène, l’environnement et même le stress quotidien. Prendre soin de son visage passe ainsi par une meilleure compréhension du dialogue constant entre flore cutanée, production de sébum et qualité de vie.
Cet axe holistique pave la voie vers une redéfinition des standards de beauté, désormais axés sur la diversité biologique de la peau plutôt que sur un idéal de pureté abstrait. De quoi encourager chacun(e) à remettre la science et la connaissance de soi au centre de sa routine beauté, en gardant à l’esprit que soutenir le microbiome reste l’un des moyens les plus efficaces d’afficher un teint lumineux et équilibré sur la durée.













